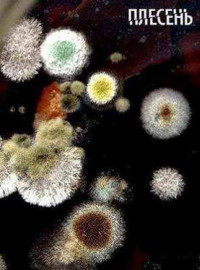
(2008)

Плесень (2008)
- Год выхода: 2008
- Страна: Россия
- Перевод: Оригинал
- Качество: DVDRip
- Жанр: Док / ТВ Передачи
Плесень появилась на Земле 200 миллионов лет назад. Она убивает и спасает от смерти. Ее называют «хлебом дьявола» и «плевком бога». Она сказочно красива, но вызывает отвращение. Она вездесуща и неистребима, и сопровождает человека от рождения до смерти. Возможно, именно она является хранительницей жизни на Земле, но способна превратиться в «чуму XXI века».
И мы даже не предполагаем, какие древние тайны и скрытые силы таит в себе эта проклятая и благословенная… плесень! Мы сталкиваемся с ней постоянно, но либо не замечаем, либо избавляемся от нее. Человек слишком самонадеянно считает себя хозяином на Земле, на самом деле мир принадлежит плесени. И если она захочет вытеснить человека из своей зоны обитания, она это сделает.
И мы даже не предполагаем, какие древние тайны и скрытые силы таит в себе эта проклятая и благословенная… плесень! Мы сталкиваемся с ней постоянно, но либо не замечаем, либо избавляемся от нее. Человек слишком самонадеянно считает себя хозяином на Земле, на самом деле мир принадлежит плесени. И если она захочет вытеснить человека из своей зоны обитания, она это сделает.
Проверяйте новые серии и качество во всех плеерах!
Плеер 5
Плеер 4
Плеер 3
Плеер
Свет
Добавить в закладки
 Поиск торрент раздач, пожалуйста подождите!
Поиск торрент раздач, пожалуйста подождите!


















